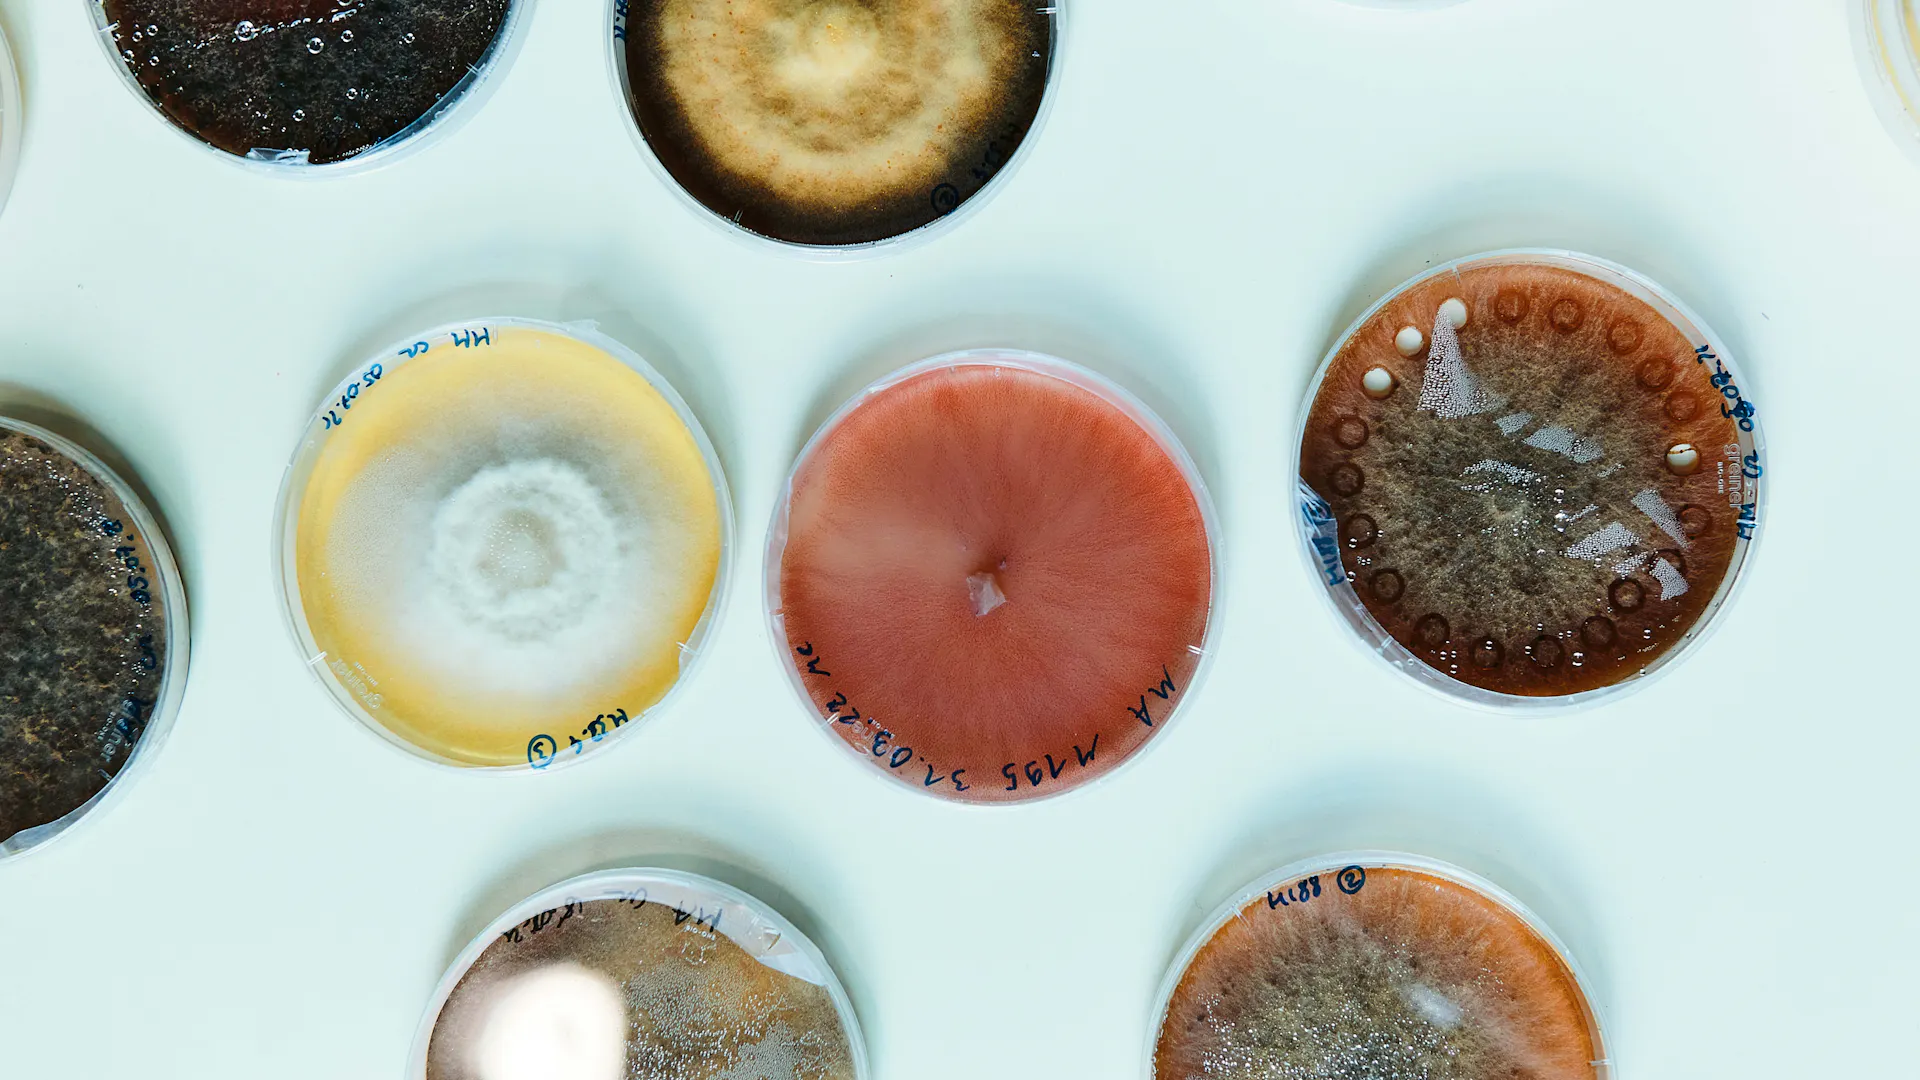

Published on 01/08/2022
Dear Readers,
Since gaining steam in the mid-1990s, globalization, with its heightened international academic cooperation, has been a driving force in fueling global economic growth and innovation, which has lifted millions of people out of poverty and created better access to healthcare in many parts of the world.
Most notably during the coronavirus crisis, this global network was instrumental in the record-breaking development and distribution of innovative vaccines and medicines that helped rein in the pandemic. But even before the healthcare crisis, breakthrough technologies such as artificial intelligence and gene therapy have been the result of intense international teamwork.
Switzerland has been a beneficiary and driver of this trend. The country has not only cemented its position as one of the world’s wealthiest economies during the past 30 years. It has grown into an innovation leader that is home to global research flagships such as the European Organization for Nuclear Research and the Paul Scherrer Institute, to name but a few.
Although cracks are appearing in this picture due to increasing geopolitical tensions and the fact that Switzerland’s academic centers have lost full access to the European Union’s coveted 95.5-billion-euro research program Horizon Europe, collaboration will remain a centerpiece of the country’s science and business communities.
Zurich, Lausanne and Basel, with their closely knit research networks of universities, private research institutes, lively startup scenes and leading pharmaceutical companies such as Roche and Novartis, are still among the world’s most innovative research hubs. They are able not only to compete with the best, but also to find new partners outside Europe.
Accelerating partnerships, therefore, remains essential, even during these increasingly challenging times. As a science-based company, Novartis considers collaboration a vital element in its efforts to innovate. This includes external collaboration with industry peers and academia, but also a growing number of stakeholders such as patient organizations and NGOs.
Reflecting the growing importance to connect with others, we have opened our Campus in Basel to third-party companies to strengthen the local research ecosystem and to intensify cooperation with highly specialized startups. We have also spurred existing partnerships with players such as the Friedrich Miescher Institute, which will move to the Campus soon.
As this issue of live magazine shows, we have created new research funding schemes in Switzerland in recent years, such as FreeNovation to help finance unorthodox research projects, and co-founded the Institute of Molecular and Clinical Ophthalmology Basel together with the local university and University Hospital.
Internally, we have also successfully launched the incubator program Genesis Labs, which allows our researchers to pursue bold projects that lie outside our core focus areas. One of these projects is now a centerpiece of the Innovative Medicines Initiative, the world’s biggest public private partnership in the life science sector.
To remain a place of scientific excellence and keep up with other top research centers in the United States, Asia and Europe, Switzerland’s scientific community should remain open for new opportunities and cultivate a bold mindset when it comes to developing fresh research avenues that are not being pursued elsewhere.
Challenging times also always create new opportunities. Switzerland has showed time and again that it can navigate crises. But a country which has produced more than 20 Nobel Prize winners should not just look back. Its legacy should be a motor to move boldly ahead and continue to do what it does best: to innovate and forge ties with the rest of the world. Novartis will continue in that same vein.
Joerg Reinhardt
Chair of the Board of Directors
"Download Live. N°11 as PDF here!"
Thanks for reading Live.Magazine
Stay connected by subscribing to our newsletter
SubscribeBy submitting your email, you consent to Novartis AG collecting and processing your email data for Novartis internal use, in accordance with our privacy policy, and by protected technical means.